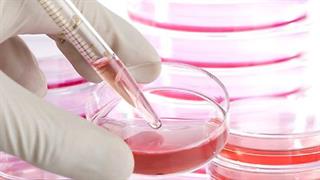
Αναγεννητική ιατρική: H δύναμη των βλαστικών κυττάρων

Δευτέρα, 15 Δεκεμβρίου 2014
Πώς διορθώνω τη χαλάρωση λαιμού;Laser, ραδιοσυχνότητες και ενέσιμα υλικά είναι ορισμένοι τρόποι αντιμετώπισης της χαλάρωσης του λαιμού. Δείτε αναλυτικά ό,τι άλλο πρέπει να ξέρετε.
Δευτέρα, 15 Δεκεμβρίου 2014
Πώς θα βγάλουμε τα γυαλιά; Οι τεχνικές της θεραπείας των ματιώνΠώς γίνεται η επέμβαση για τη διόρθωση του διαθλαστικού σφάλματος ενός οφθαλμού; Ποιες είναι οι τεχνικές.
Δευτέρα, 15 Δεκεμβρίου 2014
Aϋπνία: Λόγοι και αντίδοτα για να μην είστε…νυχτοπούλιαΔεν μπορείτε να κοιμηθείτε; Ξυπνάτε πολλές φορές μέσα στη νύχτα; Τι φταίει; Δημοφιλείς αιτίες αυπνίας και το αντίδοτό τους.
Παρασκευή, 12 Δεκεμβρίου 2014
Aνεξήγητη Υπογονιμότητα: Τι φταίει και δεν μένω έγκυος;Δυσκολία στη σύλληψη; Ποιες είναι οι βασικές εξετάσεις που διενεργεί ο γυναικολόγος υπογονιμότητας και τι γίνεται αν δεν είναι φυσιολογικές;
Παρασκευή, 12 Δεκεμβρίου 2014
Αναγεννητική ιατρική: H δύναμη των βλαστικών κυττάρωνΔιάχυτη είναι η αισιοδοξία στην επιστημονική κοινότητα για τις πολλαπλές χρήσεις των βλαστικών κυττάρων στο μέλλον και μάλιστα σε ένα μεγάλο αριθμό παθήσεων. Δείτε γιατί υπάρχει τόσος ενθουσιασμός σχετικά με την αναγεννητική ιατρική.
Παρασκευή, 12 Δεκεμβρίου 2014
Τι πρέπει να γνωρίζετε για τα παπλώματαΜετάξι, βαμβάκι, λινό…τι ύφασμα να προτιμήσω για το πάπλωμά μου; Τι πάπλωμα να επιλέξω ανάλογα με την εποχή.
Πέμπτη, 11 Δεκεμβρίου 2014
Διπολική διαταραχή: Τύποι, διάγνωση και αντιμετώπισηΗ διπολική διαταραχή περιλαμβάνει διάφορους τύπους. Πώς γίνεται η διάγνωση και πώς αντιμετωπίζεται;
Πέμπτη, 11 Δεκεμβρίου 2014
Είναι επικίνδυνος ο βελονισμός;Σε παθήσεις όπως η οσφυαλγία, ο πόνος, οι έμετοι, αλλά και διακοπή καπνίσματος., ο βελονισμός έχει πεδία επιτυχίας. Πώς όμως γίνεται η θεραπεία; Μήπως είναι επικίνδυνη;
Τετάρτη, 10 Δεκεμβρίου 2014
Πώς θα ισιώσω τα δόντια μου;Είμαι μεγάλος για σιδεράκια; Υπάρχει όριο ηλικίας για να ξεκινήσει η ορθοδοντική θεραπεία; Τι μπορεί να κάνει για τους ενήλικες; Όσα πρέπει να γνωρίζετε για να ισιώσετε τα στραβά δόντια.
Τετάρτη, 10 Δεκεμβρίου 2014
Καθημερινές συνήθειες υγείας για όλο το 24ωροΠώς θα είστε υγιείς εσείς και η οικογένειά σας; Καθημερινές συνήθειες, ώρα με την ώρα, για όλη την οικογένεια.

Ποια είναι τα οφέλη του τσαγιού Matcha
Ποια είναι τα οφέλη του τσαγιού Matcha Εφαρμογή σε smartphone κατά της πρόωρης εκσπερμάτισης
Εφαρμογή σε smartphone κατά της πρόωρης εκσπερμάτισης Στρες και αλκοόλ: Διαφορετικά αντιδρά ο εγκέφαλος ανδρών και γυναικών
Στρες και αλκοόλ: Διαφορετικά αντιδρά ο εγκέφαλος ανδρών και γυναικών Και οι δυο τύποι διαβήτη αυξάνουν σημαντικά τον κίνδυνο άνοιας [μελέτη]
Και οι δυο τύποι διαβήτη αυξάνουν σημαντικά τον κίνδυνο άνοιας [μελέτη]